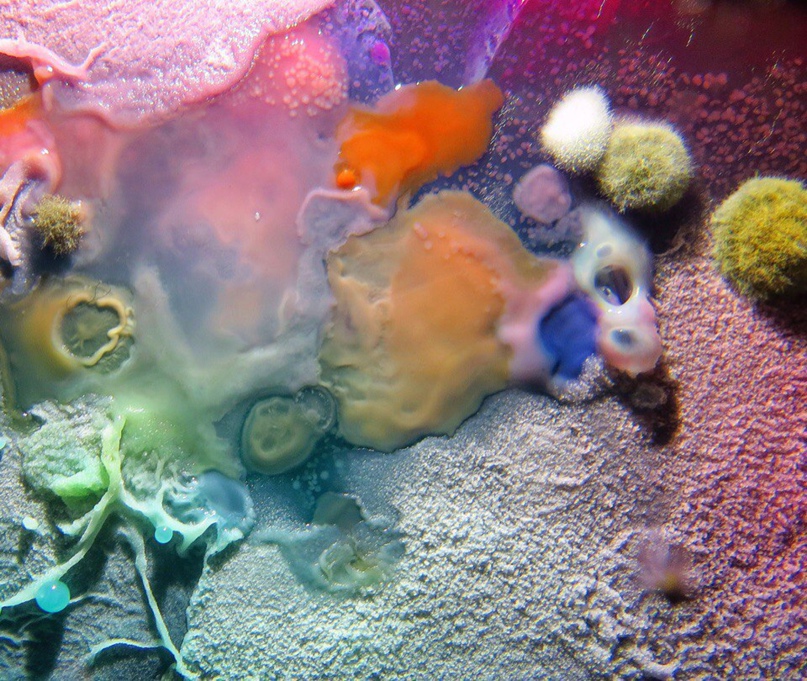

Кирилл Кучеренко
Украина, Одесса
Дата рождения: 1 февраля 2001
Родной город: Одесса
Подписчиков: 178
Страница пользователя : https://vk.com/id151510954
- Последний вход 2018-05-03 16:38:19

Кирилл Кучеренко
Украина, Одесса
Дата рождения: 1 февраля 2001
Родной город: Одесса
Главное в людях:
Notice: Undefined offset: 0 in /home/userz/web/userz.pro/public_html/application/views/index/v_vk_user.php on line 106
Главное в жизни:
Notice: Undefined offset: 0 in /home/userz/web/userz.pro/public_html/application/views/index/v_vk_user.php on line 106
Отношение к курению:
Notice: Undefined offset: 0 in /home/userz/web/userz.pro/public_html/application/views/index/v_vk_user.php on line 106
Отношение к алкоголю:
Notice: Undefined offset: 0 in /home/userz/web/userz.pro/public_html/application/views/index/v_vk_user.php on line 106
Языки: Русский, Українська, English
Источники вдохновения:
Подписчиков: 178
Страница пользователя : https://vk.com/id151510954
Кирилл Кучеренко - фото

Данная страница сгенерирована в реальном времени на лету с помощью запроса к API от соцсети ВКонтакте. На странице содержатся только открытые данные пользователей ВК, которые НЕ скрыты настройками приватности. Наш ресурс Findlik.pro НЕ собирает и НЕ осуществляет хранение персональных данных пользователей ВКонтакте.